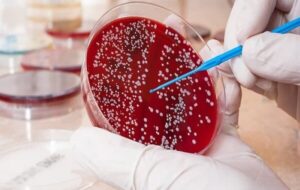
افزایش نگرانکننده سرطان روده بزرگ در ایران افزایش نگرانکننده سرطان روده بزرگ در ایران

به گزارش خبرنگار خبرگزاری مهر، با شیوع انواع سرطان در جامعه امروزی و نیاز به اصلاح سبک زندگی در پیشگیری از بیماریهای سخت، مهدی عالم رجبی، متخصص و جراح سرطانهای دستگاه گوارش در خصوص افزایش سرطان روده بزرگ پاسخ سوالات گروه سلامت خبرگزاری مهر را داد.
آقای دکتر میزان شیوع سرطانهای روده بزرگ در جامعه ایرانی چقدر است؟
برای اینکه بدانیم میزان بروز یک سرطان در یک جامعه چقدراست نیازمند آمارگیریهای دقیق هستیم؛ خوشبختانه جامعه ایران جزو جوامعی است که تا حدودی این آمارگیریها و ثبت سرطانها در آن انجام میشود و ما جامعهی دارای آمار هستیم و بر اساس آمارهایی که تا کنون احصاء شده شیوع سرطانهای روده بزرگ در ایران چیزی نزدیک به ۱۰ تا ۱۵ مورد در هر ۱۰۰ هزار نفر است که در این آمارها در مردها بیشتر است.
مردها بین ۱۶ تا ۱۷ نفر و در خانمها ۱۱ تا ۱۲ نفر در ۱۰۰ هزار نفر تخمین زده میشود؛ البته ممکن است آمارگیریها و ثبت سرطانها خیلی دقیق نباشد مانند برخی از جوامع غربی ولی قابل اتکا است و ما میتونیم روی این آمارها صحبت کنیم.
متأسفانه در طی دهه گذشته این آمارها افزایش پیدا کرده؛ شاید مهمترین دلیل آن ثبت دقیقتر آمارها باشد و روزبهروز بر دقت آن افزوده و در نتیجه به تعداد مبتلایان نیز اضافه میشود.
اما جای نگرانی نیست و قطعاً تغییر رژیمهای غذایی و استفاده نکردن از غذاهای فراوری شده، اصلاح سبک زندگی غربی و انجام فعالیتهای ورزشی میتواند در کنترل انواع سرطان مخصوصاً سرطانهای گوارشی تأثیر مثبت بگذارد، هرچند نمیتوان از تأثیر عمیق زندگی شهری، مصرف سیگار و الکل و البته ژنتیک نیز غافل بود.
آیا عوامل فردی در ابتلاء به سرطان بیشتر مهم هستند یا عواملی که در اجتماع وجود دارند؟
برای بروز سرطانهای دستگاه گوارش و سرطانهای روده بزرگ باید گفت که به نظر میرسد دلایل فردی بیشتر موثرند؛ عوامل مهمی مانند ژنتیک، همچنین سبک زندگی و تغذیه و نوع غذاهایی که میخوریم مانند غذاهای دارای فیبر کم و گوشت قرمز، مواد غذایی دارای نگهدارنده، غذاهای کهنه که در یخچال نگهداری میشوند، مصرف سیگار، قلیون و الکل و موارد مشابه با بالا رفتن سن تأثیر بسیار زیادی در ابتلاء به سرطان روده بزرگ دارند.
اما در خصوص عوامل اجتماعی مانند فقر اجتماعی، آلودگی محیط زیست و آلودگیهای شهری و هوا استرسهای ناشی از زندگی شهرنشینی و سایر مواردی که به صورت اجتماعی ما با آنها مواجه هستیم میتوانند در شیوع این بیماری مؤثر باشند و در نهایت اگر بخواهیم یک خطی بکشیم و اینها را از هم جدا کنیم شاید خیلی دقیق نباشد ولی به نظر من چیزی حدود ۶۰ الی ۷۰ درصد با عوامل فردی مرتبط است.
اگر زود هنگام سرطان روده بزرگ را تشخیص بدهیم چه فوایدی دارد و اگر با تأخیر روند درمان صورت پذیرد چه خطراتی میتواند داشته باشد؟
یک موضوع بدیهی وجود دارد که سرطانها هرچه زودتر تشخیص داده شوند درمانشان هم آسانتر و هم ارزانتر و هم مؤثرتر میشود. در مورد سرطان روده بزرگ به دلیل اینکه زمان میبرد تا این بیماری پیشرفت کند قطعاً همین قانون وجود داره، یعنی ما اگر سرطان در مراحل خیلی ابتدایی تشخیص دهیم با یک عمل خیلی ساده میتوایم آن را کاملاً برطرف کنیم، اگر کمی بیشتر پیشرفت کرده باشد خب عمل جراحی سختتر و بزرگتر میشود و یا حتی ممکن است.
مجبور به اضافه کردن شیمی درمانی باشیم تا بتوانیم به آن غلبه کنیم، ولی اگر خدایی نکرده سرطان را در مراحل بالاتر تشخیص دهیم گاهی مواقعها علیرغم جراحی، رادیوتراپی و شیمی درمانی هرگز درمان قطعی برای بیمار را نمیتوانیم داشته باشیم و فقط میتوانیم یکسری درمان اصطلاحاً پلی ایتی یا درمانهای تسکینی انجام دهیم یا به عبارت دیگر فقط زندگی را برای فرد راحتتر کنیم لذا این موضوع خیلی بدیهی است که هرچه زودتر ما بتونیم سرطان را در بدن کشف کنیم درمان مؤثرتر، ارزانتر و سادهتری را برای فرد خواهیم داشت.
آیا روشهای نوین درمان جراحی الان در کشور ما وجود داره خیر؟
شاید بسیاری از مردم ندانند که در حال حاضر ایران در درمان سرطانها نه تنها عقب نیست بلکه جز کشورهایی است که در درمان سرطانها حرف برای گفتن دارد. در حوزه عملهای جراحی هر مقدار تکنولوژی در کشور داشته باشیم به بهترین نحو ممکن از آنها استفاده میکنیم، در حال حاضر درمانهای لاپاراسکوپی یعنی جراحیهای کم تهاجمی برای سرطانهای روده بزرگ در کشور ما انجام میشود، نکته مهمتر این است که در برخی از مراکز دانشگاه علوم پزشکی ایران برای دانشجویان فوق تخصصی انواع درمانهای نوین سرطان آموزش داده میشود.
همچنین در شیمی درمانی داروهای مهمی در کشور ساخته میشود. من به عنوان کسی که سالهاست در امر درمان سرطان روده بزرگ کار میکنم به نظرم میرسد که بیماران ما در داخل کشور انواع روشهای درمانی در سراسر کشور دسترسی دارند.
آیا در جوامع پیشرفته هم شیوع سرطانهای گوارشی بالا رفته؟
بله، شیوع سرطانهای گوارشی و کلاً بیماریهای گوارشی در کل دنیا افزایش پیدا کرده در یک بازه ۳۰ ساله، سال ۱۹۹۰ تا ۲۰۲۰ شیوع بیماریهای گوارشی ۷۰ درصد و مرگ و میر ناشی از آن چیزی حدود به ۳۵ درصد افزایش پیدا کرده است. البته بیشتر آمار شیوع و مرگ و میر مربوط به کشورهای در حال توسعه میباشد زیرا کشورهای در حال توسعه هم سبک زندگیشان در حال تغییر است و هم شرایطی ایجاد شده که میتوانند ثبت بیشتری از آمار این بیماریها را داشته باشند؛ بعضی از کشورها هستند که اصلاً هیچگونه ثبتی از این بیماریها ندارند ولی بعضی کشورها هستند که میتوانند بیماریها را ثبت کنند و گزارش دهند.
در کشورهای بسیار پیشرفته و توسعه یافته هم به صورت کلی آمارهای بیماریهای گوارشی و سرطانهای روده بزرگ بسیار بالاست و پیشبینی تا چند سال آینده در سراسر دنیا سرطان روده بزرگ شایعترین سرطان باشد که افراد به آن مبتلا میشوند.
شما به عنوان یک متخصص در درمان سرطانهای گوارشی چه پیام بهداشتی و پیشگیرانه به افراد جامعه میدهید؟
مهمترین اصل در درمان سرطانهای گوارشی و به خصوص سرطان روده بزرگ یافتن این بیماری در مراحل ابتدایی است و چون ما با سرطانی روبرو هستیم که قابل پیشبینی و پیشگیری است میتوانیم این بیماری را در مرحله اولیه تشخیص دهیم. لذا پروتکلهایی داریم که افراد مشکوک را باید زودتر اسکرینینگ کنیم یعنی بیماریابی کنیم. توصیه بنده این است از ۴۵ سالگی حتماً همه افراد باید یک کلونوسکوپی داشته باشند؛ این کلونوسکوپی به آنها کمک میکند که اگر اتفاقی در درون روده در حال وقوع است بتوانیم آن را در مراحل اولیه کشف و خیلی راحتتر بر آن غلبه کنیم.
افرادی که در خانواده فرد مبتلا به سرطانهای روده بزرگ، معده، پانکراس داشتهاند باید زودتر این غربالگریها را انجام دهد و یا حتی اگر یک فرد خانواده زیر سن ۵۰ سال دچار سرطان شده ما حتماً میگوئیم سایر اعضای خانواده این غربالگریها زودتر از ۴۵ سالگی انجام دهند. در پایان برای همه مردم خوب کشور آرزوی سلامتی میکنم.

ارسال نظر شما
مجموع نظرات : 0 در انتظار بررسی : 0 انتشار یافته : 0